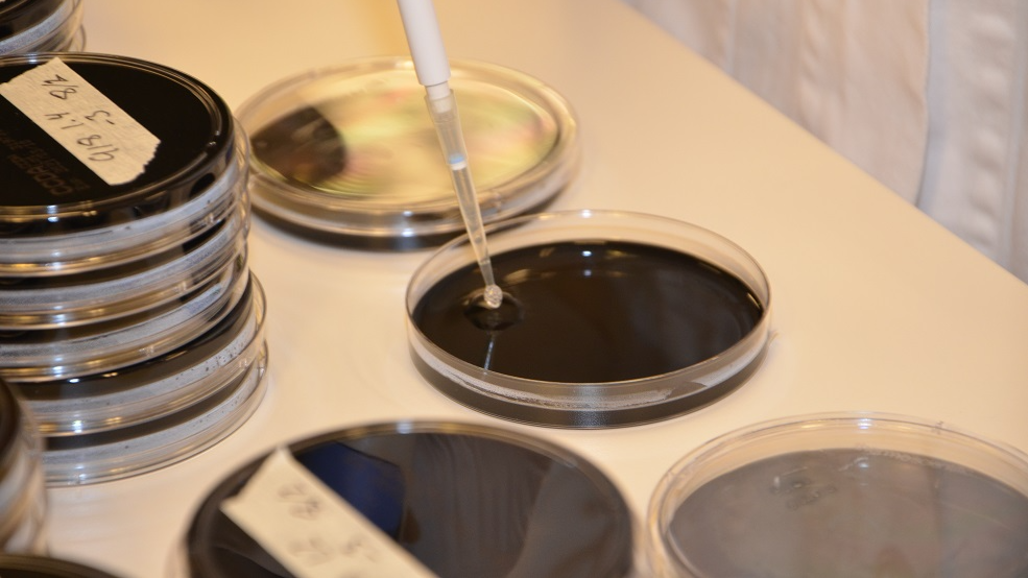

Frysning av kycklingkött minskar mängden Campylobacter
De flesta Campylobacter-infektioner hos människor är sporadiska fall, ofta kopplade till privata hushåll. Fjäderfäkött anses vara den främsta källan till campylobacterios och det finns betydande risker vid hantering av Campylobacter-kontaminerad kyckling i köket.
En förebyggande åtgärd för att minska antalet bakterier i kött är frysning.
Överlevnaden av olika typer av Campylobacter under frysning har undersökts i två examensarbeten vid SLU. Dessutom studerades riskfaktorer vid hantering av kontaminerat fjäderfäkött i köket. Tvåhundra bitar kycklingfilé kontaminerades innan frysning med Campylobacter av olika typer och koncentrationer. I köket analyserades prov från händer, köksredskap och skärbräda före och efter rengöring.
Den största minskningen av koncentrationerna av Campylobacter i frysen skedde under de första fyra dagarna, därefter planade minskningen ut. Innan frysning var det 130 000 – 220 000 Campylobacter per gram kycklingfilé. Efter sju veckor i frysen hade detta minskat till 1 600 – 20 000. Den typ av bakterien (ST-918) som orsakade många fall av campylobacterios vid utbrottet 2016-2017 var den som hade högst överlevnad efter frysning.
Campylobacter isolerades från alla simulerade köksprover. Den högsta överföringen skedde genom otvättade handskar och oavtorkad skärbräda. Överföringen från sköljda händer och avtorkad skärbräda var lägre, men höga koncentrationer (≥100 campylobacter/ml sköljvätska) fanns ändå kvar. Detta är en trolig källa till smittöverföring i köket, då endast en liten mängd bakterier (<1000) krävs för att orsaka sjukdom. Studien visar att god hygien i köket, såsom att diska skärbrädor och knivar i diskmaskin efter användning samt noggrann handtvätt, är av stor betydelse för att undvika campylobacterios.
Länk till publikationen
https://doi.org/10.1016/j.foodcont.2022.109471
Referens
Eriksson D, Råhlén E, Bergenkvist E, Skarin M, Rydén J, Hansson I. 2023. Survival of Campylobacter jejuni in frozen chicken meat and risks associated with handling contaminated chicken in the kitchen. Food Control 145, 109471.
Kontakt
-
PersonIngrid Hansson, professorHBIO, Bakteriologi, virologi, livsmedelssäkerhet och veterinärmedicinsk folkhälsa